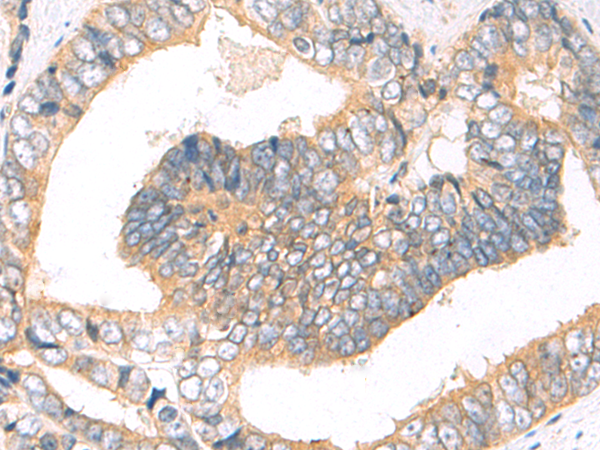

|
Background: |
The protein encoded by this gene is a member of the STAT family of transcription factors. In response to cytokines and growth factors, STAT family members are phosphorylated by the receptor associated kinases, and then form homo- or heterodimers that translocate to the cell nucleus where they act as transcription activators. This protein mediates the signal transduction triggered by various cell ligands, such as IL2, IL4, CSF1, and different growth hormones. It has been shown to be involved in diverse biological processes, such as TCR signaling, apoptosis, adult mammary gland development, and sexual dimorphism of liver gene expression. This gene was found to fuse to retinoic acid receptor-alpha (RARA) gene in a small subset of acute promyelocytic leukemias (APLL). The dysregulation of the signaling pathways mediated by this protein may be the cause of the APLL. |
|
Applications: |
ELISA, IHC |
|
Name of antibody: |
STAT5B |
|
Immunogen: |
Fusion protein of human STAT5B |
|
Full name: |
Signal transducer and activator of transcription 5B |
|
Synonyms: |
STAT5 |
|
SwissProt: |
P51692 |
|
ELISA Recommended dilution: |
500-10000 |
|
IHC positive control: |
Human lymphoma and human breast cancer |
|
IHC Recommend dilution: |
10-50 |

購物車
購物車 幫助
幫助
 021-54845833/15800441009
021-54845833/15800441009
